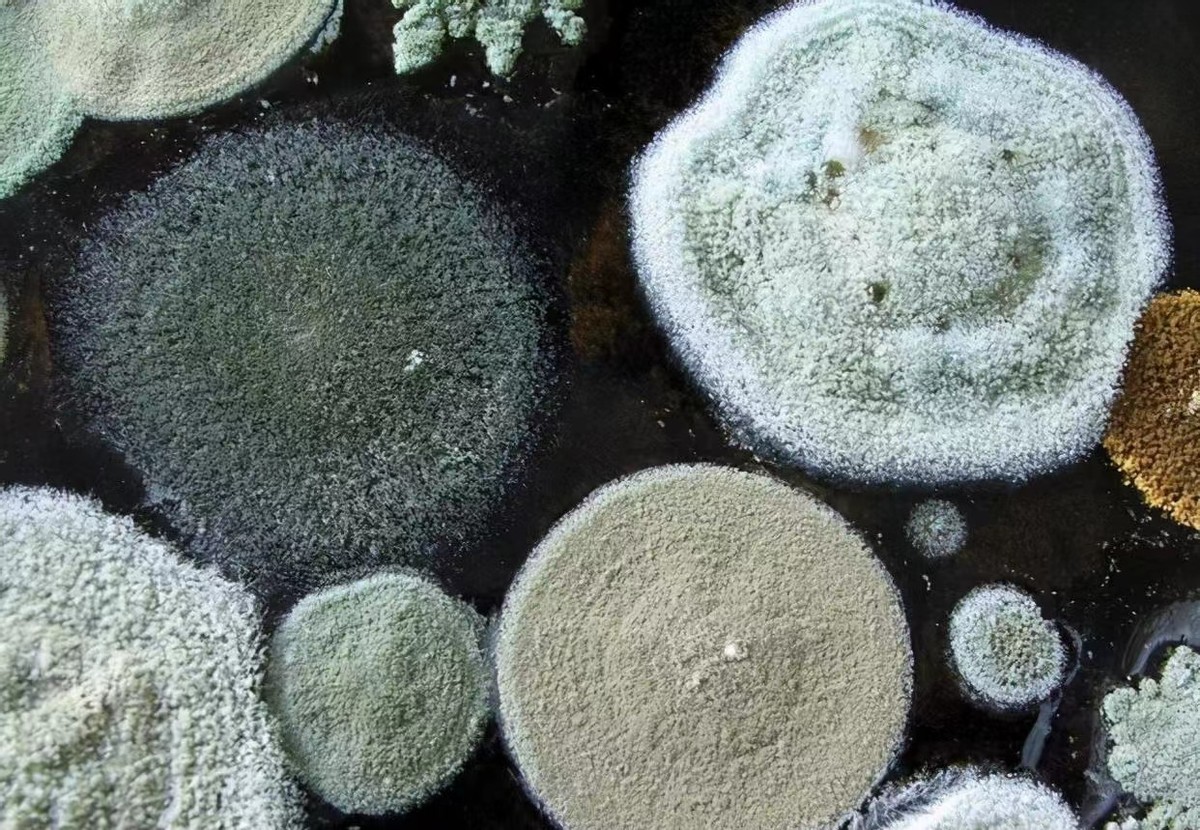
家里这些东西，看似干净实际却很“脏”，不懂得建议看看

家里这些东西,看似干净实际却很“脏”,不懂得建议看看

文章图片

文章图片

文章图片

文章图片

文章图片
文章图片

文章图片

一件衣服穿久了会脏 , 一个东西用久了会破 , 不可避免地家里的东西长时间不清洁更换 , 也会变得不干净 。
家里是我们住的地方 , 所以很多地方和东西都不能够含糊过去 , 有的人在家里呆久了反而浑身难受瘙痒 。
那这一定是因为你的家里很久没有清洁过了 , 那些常年不动的家具用品总会沾染上各样的脏东西和细菌 。
【家里这些东西,看似干净实际却很“脏”,不懂得建议看看】
有时候对待家里的东西真的不能能省则省 , 食品是有保质期的 , 同样家具用品也是 , 物尽其用也要做到换得及时!
本期给大家排查那些自己在家里不会发现的“脏东西” , 看完之后也要记得及时更换呀!
[床单
一个舒服的床单是很容易给大家带来幸福感的 , 床单也是在我们的生活里占据了很重要的位置 。
每天都要在上边呆上好几个小时 , 所以床单的使用率还是蛮高的 , 而且大家每天晚上睡觉都会分解新陈代谢 , 再加上平时从外边带来的脏东西 , 就会有很多小颗粒停留在床上 。
所以床单就会有很多人忽视 , 它也是一个需要经常定期更换的家具物品 , 不容小觑 , 若是忽略了会造成皮肤问题 。
之前我对于床单也是忽略了 , 用的时间久了之后身上总会莫名其妙地出现一些小红点和痘痘 , 后来才发现原来是螨虫搞的鬼!
现在很多人针对床单问题会在家里备上[除螨喷雾剂
, 我用过之后就再也没出现过哪些问题 , 推荐给大家!
它的成分不含任何化学成分 , 可以说是无害无污染的 , 纯天然的植物精油就算是老人小孩都可以放心使用 。
建议大家买回家之后每隔半个月就在床单上喷洒一点 , 这样不仅除螨而且也达到了清洁的效果 。
当然还有沙发、衣柜地毯等的各种地方你都可以去喷一喷 , 这些家具一般都不太方便清洁 , 所以你每隔一段时间喷上几次 , 效果也是不错的 。
[牙刷
对待口腔健康 , 牙刷和牙膏就是必备的 , 我们一天吃的喝的东西很多 , 若是不按时定期的清洁口腔 , 那细菌是很多的 。
不仅我们的口腔需要经常清洁 , 牙刷也是!一个牙刷在用了三个月之后就建议大家更换 , 若是长时间不更换反而适得其反了 。
特别声明:本站内容均来自网友提供或互联网,仅供参考,请勿用于商业和其他非法用途。如果侵犯了您的权益请与我们联系,我们将在24小时内删除。
